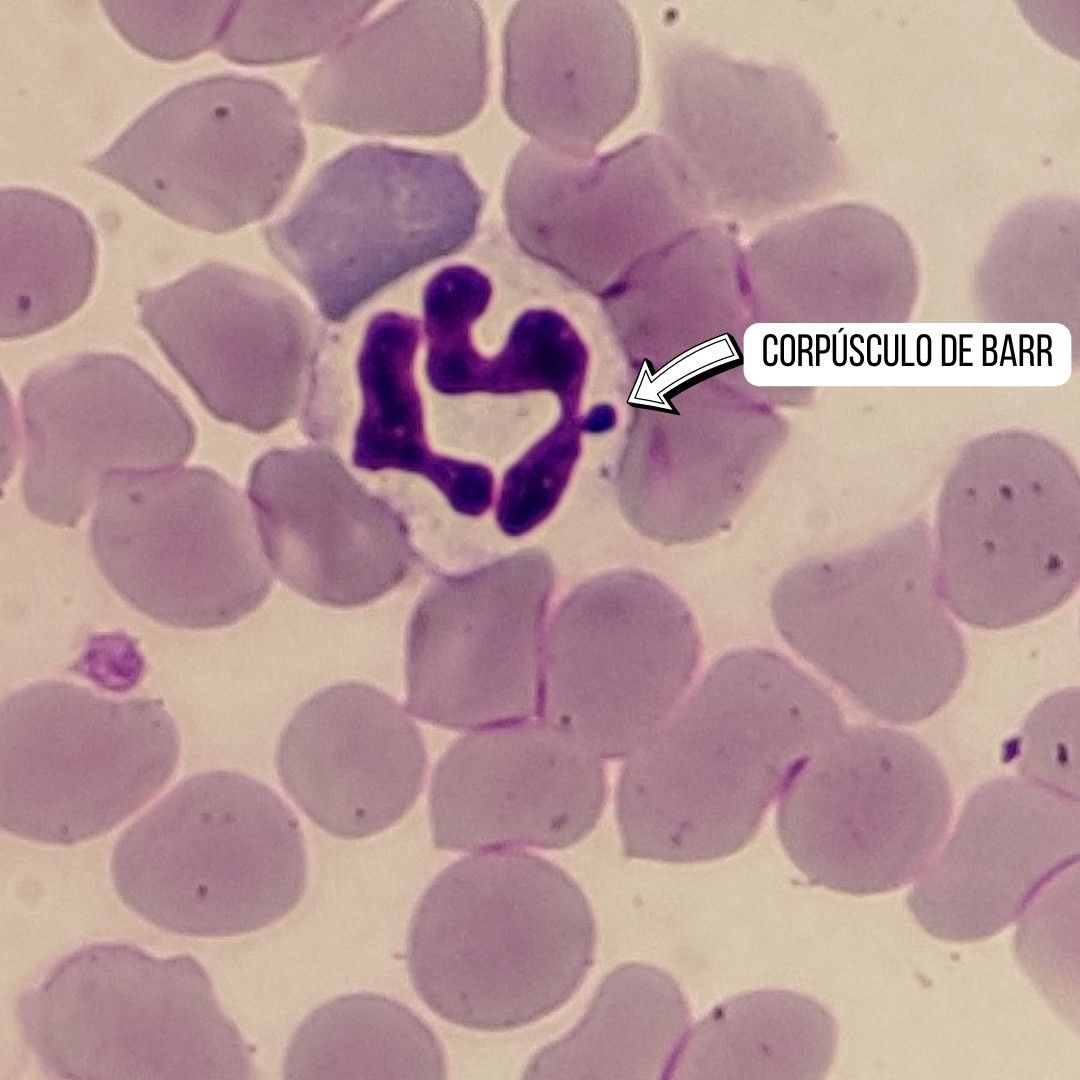

É só para rir ou para chorar de tanto rir da imbecilidade ululante?
O deputado trans, tão ignorante que sequer conhece o conceito biológico de gênero e espécie, é um exemplo claro do desastre que foi a revisão da psicopatologia clínica e instituição do tal DSM – diagnostico de saúde mental, no qual removeram da classe F (doenças mentais) no CID (classificação internacional de doenças) os LGBTQIAPN+, como se distúrbios mentais pudessem ser resolvidos e curados na base da canetada.
É simples diferenciar homem de mulher, bastando um microscópio, corante de giemsa (é com M, mesmo) e uma gota de sangue periférico, que pode ser tirado da ponta de um dedo, mesmo.
Mulheres tem, nos núcleos de seus glóbulos brancos, uma condensação chamada de corpúsculo de Barr, que é um cromossomo X inativo. Se nos glóbulos brancos da “mulher trans” Érika Hilton não forem encontrados os corpúsculos de Barr, ela não é mulher… É HOMEM e não adianta espernear, babar, resfolegar.
[Voltar]